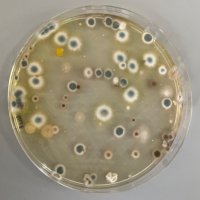
MicroMad (@micro_mad) 's Twitter Profile Photo

DETECTIVE
@detective_amr
DETECTIVE: Dissemination and resistance mechanisms of carbapenem-resistant Gram-negative bacilli
Email: [email protected]
ID: 1171355814172512256
10-09-2019 09:33:51
78 Tweet
328 Followers
20 Following



Congratulations to Xiaoting Hua and team 💫 on his study providing insights into the co-evolution of #Acinetobacter baumannii and a clinical imipenem resistance plasmid. onlinelibrary.wiley.com/doi/abs/10.111… Willem van Schaik @[email protected] Belinda Loh Rob Moran

🚨 New @EMBARK_JPIAMR #AMR digest * Phage-plasmids /@UGene2020 * Acinetobacter /Rob Moran * Dataset for benchmarking ARGs tool /Amos Raphenya * Light-activated resistance /Michael Sheets * --exclude_nudge in rgi run /Svetlana Ugarčina Perović Luis Pedro Coelho & more! 👇🏼 antimicrobialresistance.eu/2022/06/27/amr…



Our latest paper is out now in Microbiology Spectrum! journals.asm.org/doi/10.1128/sp…


This study in #MGen from Ann Snaith et al. investigates #AMR in ESBL-producing #Ecoli colonizing travellers to Laos. @alanmcn1. doi.org/10.1099/mgen.0…

Very excited to be attending CoCoMad '23 Cotteridge Park this Saturday representing IMIBirmingham 🧫Come and say hi to our team Rob Moran Dr Lilly Cummins Freya Allen Dr Ross McInnes Izzie Potterill

